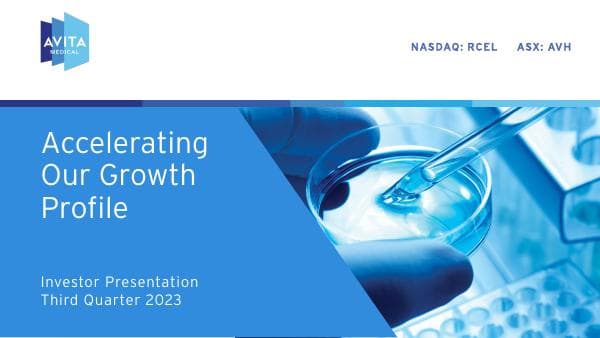
Avita

GECC-4Q23-Investor-Presentation-vFINAL-FINAL
Loading viewer...
presentation
Format: PDF presentation
GECC-4Q23-Investor-Presentation-vFINAL-FINAL by General Electric.
Loading viewer...
presentation
Format: PDF presentation
GECC-4Q23-Investor-Presentation-vFINAL-FINAL by General Electric.

presentation

presentation
Consolidated Edison

presentation
BioNTech SE

presentation
Gibraltar Industries
presentation
Agiliux